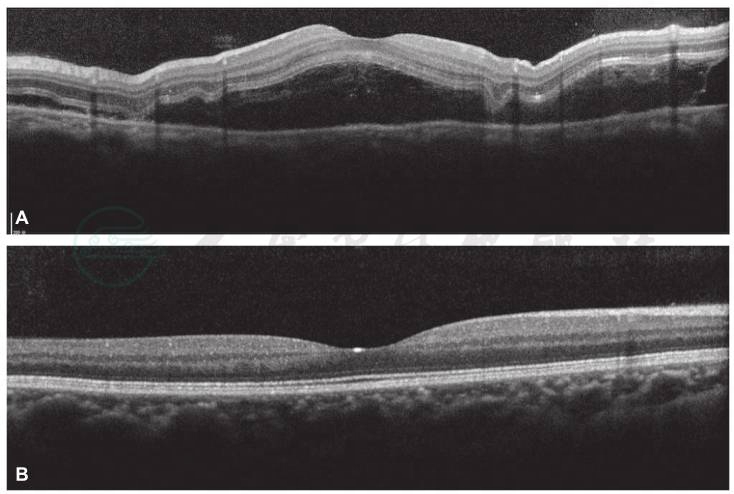

纪海霞、周海英、陈慧茹、彭晓燕
后巩膜炎是后极部到赤道部巩膜的炎症性疾病,按表现可分为弥漫性和结节性后巩膜炎两种类型。结节性后巩膜炎比较少见,常单眼发病,女性发病率高于男性,表现为非色素性的视网膜下肿块,伴邻近视网膜下液及脉络膜视网膜皱褶。由于肿块的存在,容易误诊为肿瘤性疾病,文献有类似报道。但肿块位于赤道部,引发后极部类原田病表现的情况鲜有报道。2015年到我院就诊一例类原田氏病表现的单眼后巩膜炎,现报告如下。
1例35岁女性,主因“无明显诱因左眼突然视物模糊4天”就诊于我院,间接检眼镜下可见左眼后极部至颞下赤道部多发泡状视网膜脱离,颞下赤道部可见与眼底颜色类似的局部隆起病灶,右眼正常。荧光素眼底血管造影(fundus fluorescein angiography,FFA)、吲哚青绿血管造影(indocyanine green angiography,ICGA)及相干光断层扫描(optical coherence tomography,OCT)检查左眼类似原田氏病表现,进一步眼部彩超及眼眶MRI检查提示左眼颞下赤道部隆起病灶非肿瘤性,倾向于炎症病灶,诊断为“结节性后巩膜炎”,使用局部及全身糖皮质激素治疗。自发病到开始口服激素治疗历时11天,对侧眼始终正常,无类似表现。治疗后患者恢复良好。
后巩膜炎;原田病;单眼;视网膜脱离;结节性
患者女性,35岁。主因“无明显诱因左眼突然视物模糊4天”于2015年1月9日就诊于首都医科大学附属北京同仁医院眼科门诊。眼部检查:裸眼视力右眼0.8,左眼眼前指数;双眼眼压正常;双眼前节未见明显异常;右眼眼底正常,左眼眼底后极部至颞下赤道部可见多发泡状视网膜脱离,颞下赤道部可见与眼底颜色类似的实性隆起肿块(图1)。为进一步明确病变的性质,进行了FFA、ICGA、OCT、眼部彩超及眼眶MRI检查,并采血进行风湿免疫疾病及乙肝、丙肝、梅毒、HIV、结核等感染性疾病相关检查。FFA早期可见左眼后极部多发点状强荧光,伴后极部至颞下赤道部斑片状弱荧光,颞下实性肿块对应处可见斑驳样强荧光病灶,晚期左眼后极部多湖样荧光积存,颞下病灶强荧光增强(图2)。ICGA早期可见左眼后极部至颞下赤道部多发湖样弱荧光,颞下赤道部实性肿块对应处可见斑片状略强荧光,其附近涡静脉壶腹扩张,晚期上述多发湖样弱荧光内少量强荧光积存,颞下略强荧光病灶中心呈弱荧光,环以略强荧光(图2)。OCT可见左眼黄斑区多发神经上皮脱离,其内可见点状及膜状中高信号(图3)。眼部彩超提示左眼颞下玻璃体腔内可探及隆起实性病变,大小约6.0mm×5.3mm×1.9mm,内回声不均匀,其内无血流信号,伴视网膜脱离(图4)。眼眶MRI提示左侧眼环后下壁偏颞侧可见小弧形及小结节状等T1、等T2信号影,大小4.5mm×2mm,增强扫描信号明显强化,考虑炎症性病变可能性大。风湿免疫相关检查及感染相关检查均阴性。自发病至上述检查结果回报历时11天,右眼始终正常。其间左眼球后注射甲泼尼龙40mg,注射后1周患者视力恢复至0.5,检查眼底可见后极部神经上皮脱离明显消退,颞下隆起肿块仍可见。综合上述检查结果及对局部激素治疗敏感,诊断为“左眼结节性后巩膜炎”,并给予口服泼尼松治疗,剂量1mg/kg,逐渐减量并停用,治疗时间共计3个月,患者恢复良好,最终左眼神经上皮脱离及颞下肿块完全消失,视力恢复至1.0,随访1年无复发(图5)。

A.左眼后极部可见多发泡状视网膜脱离;B.左眼颞下赤道部实性隆起肿块(图中箭头所示);

C.右眼眼底正常
图1 眼底彩色照相

图2 FFA及ICGA检查
A、C.FFA早期后极部点状强荧光及多发斑片状弱荧光,颞下赤道部隆起略强荧光病灶,周围斑片状弱荧光与后极部弱荧光相连;B、D.ICGA早期后极部至颞下赤道部多发斑片状弱荧光。

E、G.FFA晚期左眼后极部至颞下赤道部多湖样强荧光积存,颞下赤道部隆起病灶呈强荧光;F、H.ICGA晚期左眼后极部至颞下赤道部可见多湖样弱荧光,其内少量强荧光,颞下赤道部病灶呈略弱荧光,周围环以强荧光。

I、J.右眼FFA及ICGA未见异常
图2 FFA及ICGA检查
图3 OCT检查
A.左眼可见黄斑区多发神经上皮脱离及视网膜外层膜样中高信号;B.右眼黄斑区正常。
引自:主编:.同仁眼科疑难病例精析:同仁眼科临床病例讨论会1.第1版.ISBN:978-7-117-33030-5

图4 眼部彩超检查
视盘颞下方玻璃体腔内可探及一边界清晰的隆起实性病变,其内回声不均匀,未见血流信号;其表面可探及与其相连的带状回声,其上可见血流信号,考虑球内占位伴渗出性视网膜脱离。
引自:主编:.同仁眼科疑难病例精析:同仁眼科临床病例讨论会1.第1版.ISBN:978-7-117-33030-5

图5 治疗后左眼情况
A~C.分别为治疗后2天左眼后极部彩色照相、颞下赤道部彩色照相及黄斑区OCT,可见多发神经上皮脱离明显吸收,颞下赤道部隆起病灶仍可见。

D~F.分别为治疗后3个月左眼后极部彩色照相、颞下赤道部彩色照相及黄斑区OCT,可见黄斑区结构基本恢复正常,颞下赤道部病灶完全吸收,患者视力恢复至1.0
图5 治疗后左眼情况
A~C.分别为治疗后2天左眼后极部彩色照相、颞下赤道部彩色照相及黄斑区OCT,可见多发神经上皮脱离明显吸收,颞下赤道部隆起病灶仍可见。
临床表现及本病例特点
结节性后巩膜炎是发生于眼球后部的良性炎症性疾病,常单眼发病,女性多见,常不伴有系统性疾病。眼部检查可见后极部至赤道部视网膜下无色素性隆起肿块,伴周围视网膜下液及脉络膜皱褶,由于肿块的存在,容易被误诊为肿瘤性疾病,文献有类似报道,B超有助于鉴别诊断,表现为较强回声肿块,伴局部巩膜增厚,可不伴T征。但结节性后巩膜炎出现类原田病表现者鲜有报道。原田病是一种肉芽肿性葡萄膜炎,双眼同时或先后发病,双眼发病间隔一般不超过1周,眼部表现为后极部多发泡状视网膜脱离,FFA早期针尖样强荧光,晚期多湖样荧光积存。与本病例后极部表现十分类似,但本病例为单眼发病,且眼底赤道部可见明确肿块,B超及眼眶MRI提示肿块倾向于炎症性,故考虑后巩膜炎可能。
治疗方案及病例启示
结节性后巩膜炎一般对糖皮质激素治疗敏感,本病例除外感染因素后口服激素治疗,起始剂量为每天1mg/kg,逐步减量,共用药3个月,而非像原田氏病一样进行长时间的全身糖皮质激素口服,治疗后恢复良好。
本病例提示我们在眼底疾病的诊治过程中,遇到表现类似的疾病要勤思考,抽丝剥茧,找出不同点加以鉴别诊断,防止漏诊或误诊。
[1]WALEED K ALSARHANI1,AHMED M ABU EL-ASRAR.Multimodal imaging of nodular posterior scleritis:case report and review of the literature. Middle East Afr J Ophthalmol,2020,27(2):134-138.
[2]YUKIKO SHIBATA,SATORU KASE,KENICHI NAMBA,et al.A case of nodular posterior scleritis simulating intraocular tumor. Int J Ophthalmol,2019,12(4):685-688.
[3]PUI YEE SIN,DAVID TA LI LIU,ALVIN L YOUNG.Nodular posterior scleritis mimicking choroidal tumor in a patient with systemic lupus erythematous:a case report and literature review. Asia Pac J Ophthalmol (Phila),2016,5(5):324-329.
[4]PETER J MCCLUSKEY,PETER G WATSON,LIGHTMAN S,et al.Posterior scleritis:clinical features,systemic associations,and outcome in a large series of patients.Ophthalmology,1999,106(12):2380-2386.
[5]RABIH HAGE,ALBERT JEAN-CHARLES,JEROME GUYOMARCH,et al.Nodular posterior scleritis mimicking choroidal metastasis: a report of two cases.Clinical Ophthalmology,2011,5:877-880.













